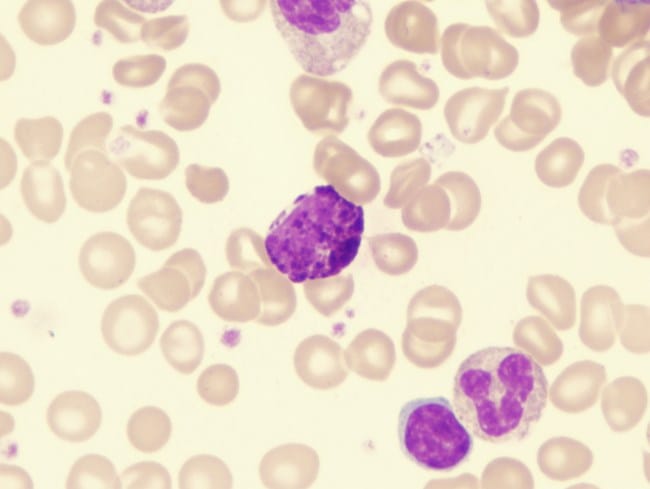
Basofil Tinggi, Inilah Penyebab dan Penanganannya - Alodokter

Basofil tinggi artinya kondisi ketika jumlah sel darah putih jenis basofil melebihi batas normal. Kondisi ini sering diketahui secara tidak sengaja melalui pemeriksaan darah rutin dan bisa berkaitan dengan infeksi, alergi berat, atau gangguan kesehatan lain yang perlu diperhatikan.
Basofil sendiri merupakan salah satu jenis sel darah putih yang berperan dalam sistem kekebalan, terutama dalam melawan infeksi dan reaksi alergi. Walaupun jumlahnya kecil dibandingkan sel darah putih lain, peningkatan kadar basofil bisa menjadi petunjuk adanya peradangan kronis, reaksi alergi parah, atau penyakit tertentu.
Oleh karena itu, memahami arti basofil tinggi penting agar Anda dapat mengenali potensi gangguan kesehatan sejak dini.
Arti Basofil Tinggi dan Penyebabnya
Basofil dianggap tinggi jika jumlahnya melebihi batas normal, biasanya di atas 100–300 sel per mikroliter darah, tergantung pada standar laboratorium dan metode pemeriksaannya. Kondisi ini disebut basofilia. Secara medis, basofilia dapat menandakan beberapa hal, seperti:
1. Infeksi kronis
Basofil tinggi dapat muncul saat tubuh menghadapi infeksi kronis misalnya tuberkulosis atau infeksi parasit contohnya cacingan. Pada kondisi ini, sistem imun bekerja lebih aktif sehingga produksi basofil ikut meningkat.
Infeksi yang berlangsung lama membuat tubuh mengaktifkan respons peradangan berkepanjangan. Hal ini bisa terlihat dari hasil pemeriksaan darah yang menunjukkan basofil tinggi.
2. Reaksi alergi berat
Pada alergi berat, seperti asma alergi atau urtikaria kronis, tubuh memproduksi zat histamin. Proses ini dapat menyebabkan basofil tinggi karena sel ini terlibat dalam respons alergi.
Reaksi alergi yang tidak terkontrol dapat memicu pelepasan zat kimia tertentu di dalam tubuh. Kondisi inilah yang membuat kadar basofil meningkat.
3. Kelainan darah
Beberapa kelainan darah, seperti leukemia myeloid kronis atau polisitemia vera, dapat menyebabkan peningkatan berbagai jenis sel darah putih. Akibatnya, kadar basofil juga ikut meningkat.
Kelainan darah seperti ini membutuhkan pemeriksaan lebih lanjut oleh dokter spesialis karena biasanya basofil tinggi muncul bersama perubahan darah lainnya.
4. Penyakit autoimun
Penyakit autoimun, seperti lupus atau radang sendi dapat memicu tubuh memproduksi basofil lebih banyak. Peradangan jangka panjang menjadi salah satu penyebabnya.
Ketika sistem imun menyerang jaringan tubuh sendiri, proses peradangan berlangsung terus-menerus. Hal ini dapat tercermin dari hasil tes darah yang menunjukkan basofil tinggi.
5. Efek obat-obatan
Beberapa obat, seperti estrogen atau obat antitiroid, dapat meningkatkan kadar basofil. Reaksi tubuh terhadap obat tertentu bisa memengaruhi sistem imun.
6. Gangguan tiroid
Gangguan tiroid, terutama hipotiroidisme, juga dapat berhubungan dengan basofil tinggi. Kondisi ini perlu dipastikan melalui pemeriksaan hormon tiroid.
Basofil Tinggi dan Penanganannya
Saat hasil pemeriksaan menunjukkan basofil tinggi, penanganannya perlu disesuaikan dengan penyebab yang mendasarinya. Dokter akan mengevaluasi apakah kondisi ini berkaitan dengan infeksi, alergi, peradangan, atau masalah kesehatan lain, kemudian menentukan langkah terapi yang paling tepat.
Berikut ini adalah beberapa penanganan yang mungkin diberikan oleh dokter:
- Memberikan antibiotik, untuk basofil tinggi yang disebabkan oleh infeksi bakteri.
- Meresepkan obat antiparasit, untuk basofil tinggi yang terjadi akibat infeksi parasit.
- Meresepkan antihistamin, untuk basofil tinggi yang berkaitan dengan reaksi alergi.
- Memberikan obat antiradang (NSAID atau kortikosteroid), untuk basofil tinggi yang disertai peradangan dan keluhan nyeri.
- Melakukan terapi sesuai diagnosis spesifik, untuk basofil tinggi yang dipicu oleh kondisi jangka panjang, seperti kelainan darah atau kanker darah.
Jika Anda baru mengetahui hasil pemeriksaan basofil tinggi dan merasakan gejala yang mencurigakan, jangan tunda konsultasi. Fitur Chat Bersama Dokter di aplikasi ALODOKTER siap membantu Anda mendapatkan penjelasan lebih lanjut. Dengan konsultasi ini, Anda bisa mendapatkan informasi yang tepat secara praktis.